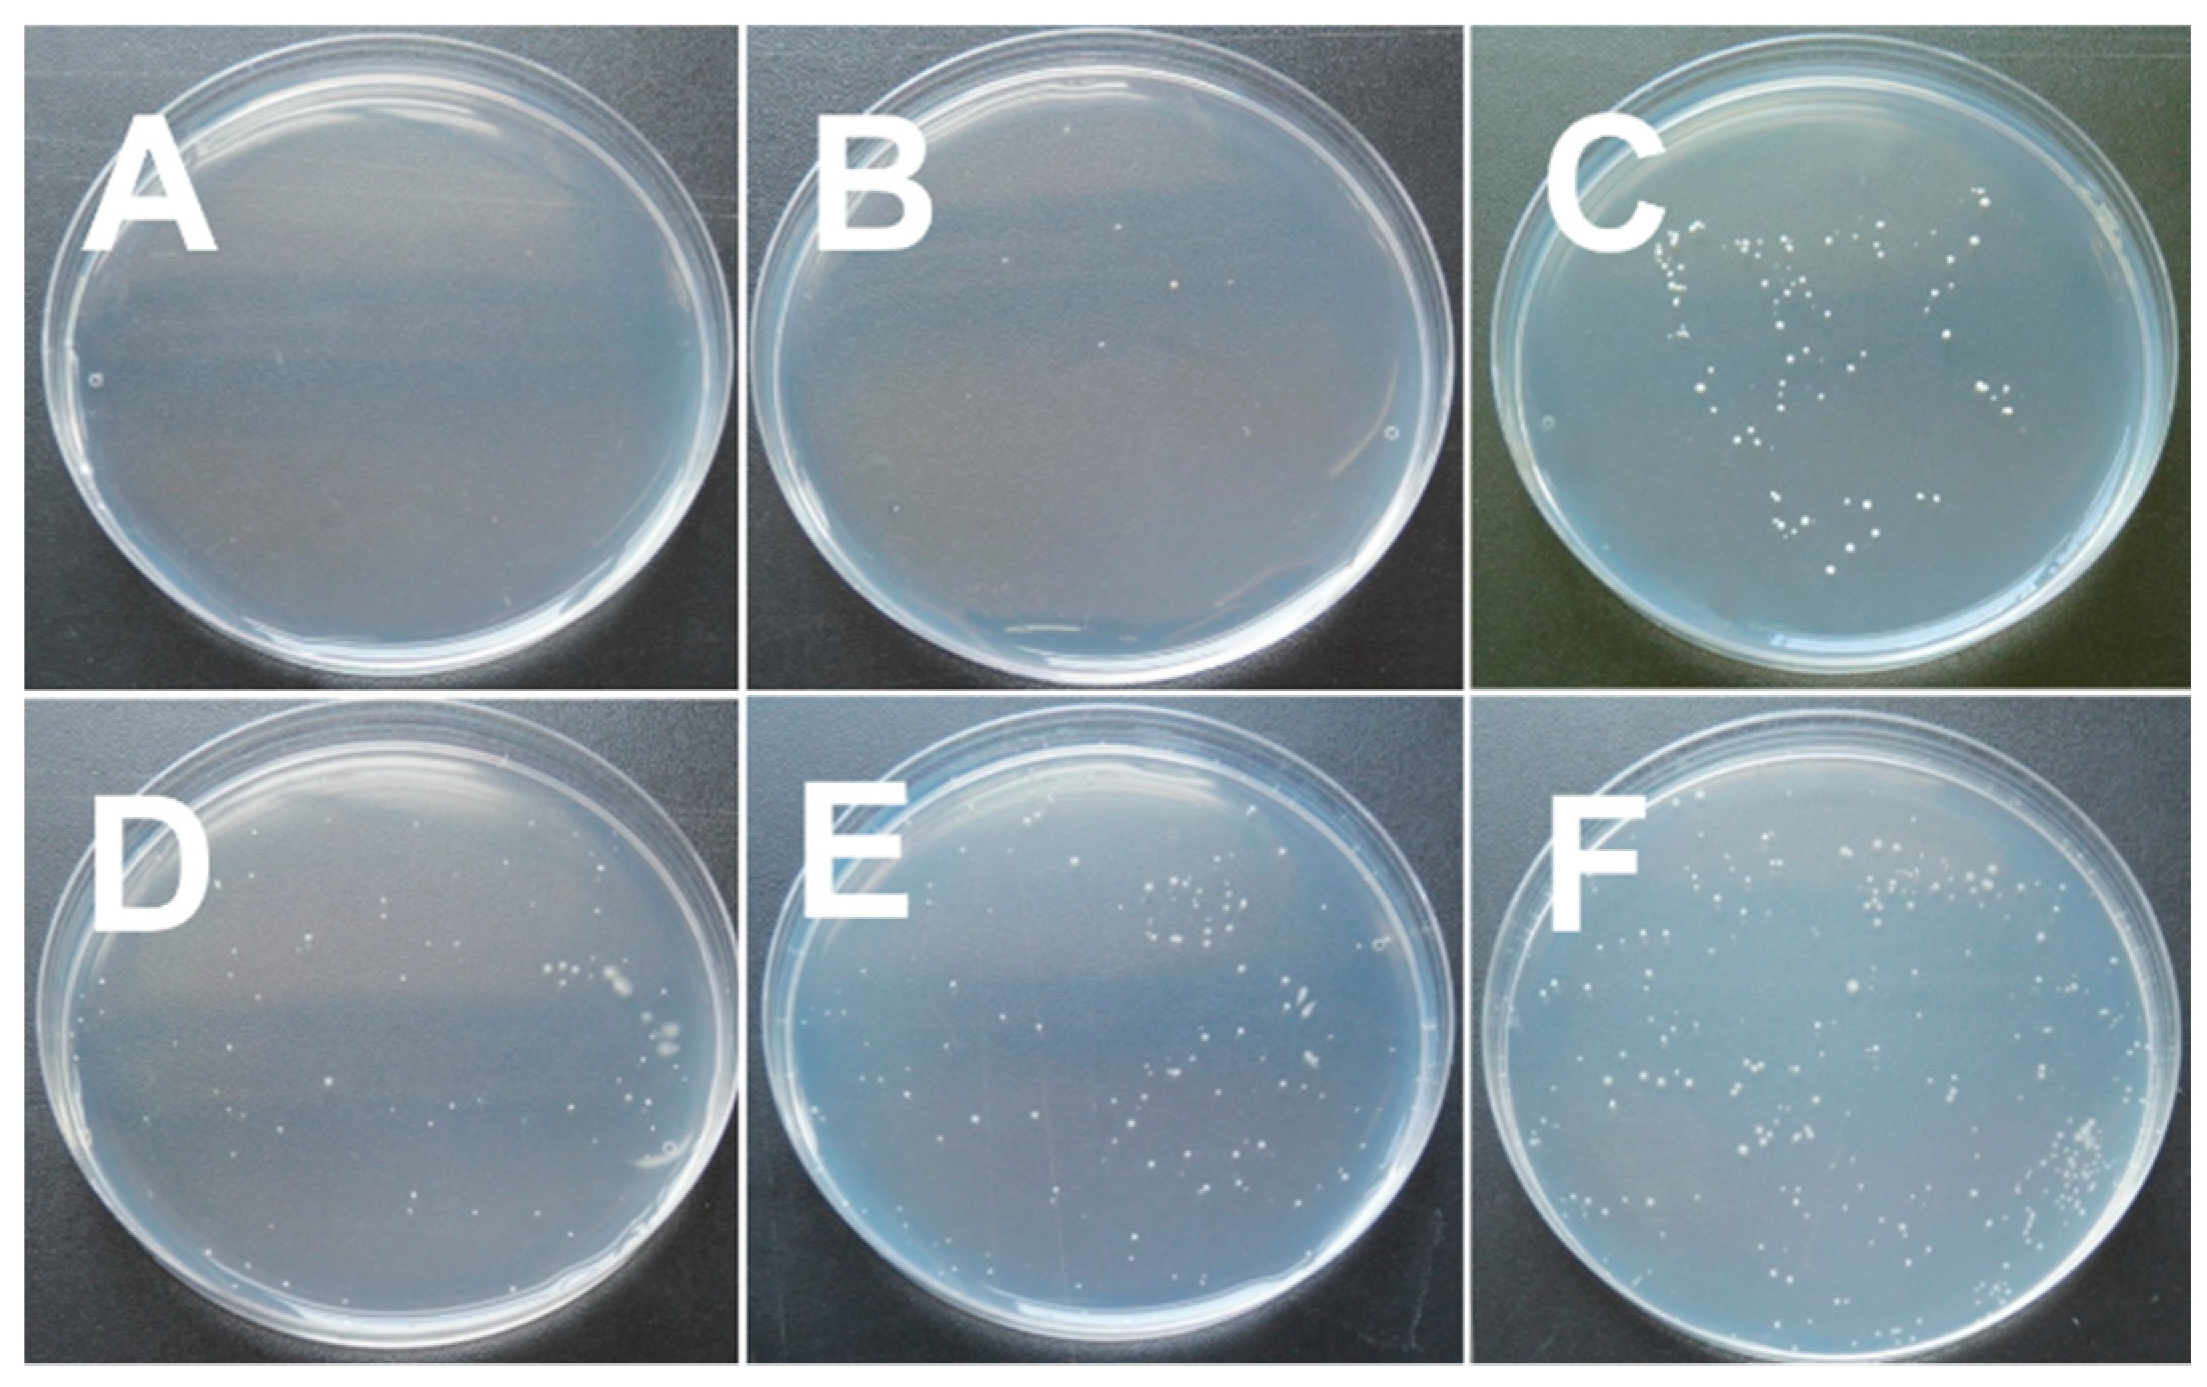

The Impact of Cross-linking Mode on the Physical and Antimicrobial Properties of a Chitosan/Bacterial Cellulose Composite
Abstract
1. Introduction
2. Materials and Methods
2.1. Materials
2.2. Sample Preparation
2.3. Cross Sectional Structure
2.4. Mechanical Qualities
2.5. Thermal Studies
2.6. Infrared Spectroscopy
2.7. Contact Angle
2.8. Film Swelling Degree, Water Vapor Absorption, and Water Activity
2.9. Antimicrobial Testing
3. Results and Discussion
3.1. Mechanical Properties
3.2. Cross Sectional Fracture Structure
3.3. Thermal Studies
3.4. Infrared Spectroscopy
3.5. Contact Angle
3.6. Water Vapor Absorption, Swelling Degree and Water Activity
3.7. Antimicrobial Testing
4. Conclusions
Author Contributions
Acknowledgments
Conflicts of Interest
References
- Werner, B.G.; Koontz, J.L.; Goddard, J.M. Hurdles to commercial translation of next generation active food packaging technologies. Curr. Opin. Food Sci. 2017, 16, 40–48. [Google Scholar] [CrossRef]
- Shahabi-Ghahfarrokhi, I.; Khodaiyan, F.; Mousavi, M.; Yousefi, H. Effect of γ-irradiation on the physical and mechanical properties of kefiran biopolymer film. Int. J. Biol. Macromol. 2015, 74, 343–350. [Google Scholar] [CrossRef]
- Cacciotti, I.; Mori, S.; Cherubini, V.; Nanni, F. Eco-sustainable systems based on poly(lactic acid), diatomite and coffee grounds extract for food packaging. Int. J. Biol. Macromol. 2018, 112, 567–575. [Google Scholar] [CrossRef] [PubMed]
- Vilela, C.; Pinto, R.J.B.; Coelho, J.; Domingues, M.R.M.; Daina, S.; Sadocco, P.; Santos, S.A.O.; Freire, C.S.R. Bioactive chitosan/ellagic acid films with uv-light protection for active food packaging. Food Hydrocolloids 2017, 73, 120–128. [Google Scholar] [CrossRef]
- Al-Naamani, L.; Dobretsov, S.; Dutta, J. Chitosan-zinc oxide nanoparticle composite coating for active food packaging applications. Innov. Food Sci. Emerg. Technol. 2016, 38, 231–237. [Google Scholar] [CrossRef]
- Wang, X.; Lou, T.; Zhao, W.; Song, G. Preparation of pure chitosan film using ternary solvents and its super absorbency. Carbohydr. Polym. 2016, 153, 253–257. [Google Scholar] [CrossRef]
- Rubentheren, V.; Ward, T.A.; Chee, C.Y.; Nair, P.; Salami, E.; Fearday, C. Effects of heat treatment on chitosan nanocomposite film reinforced with nanocrystalline cellulose and tannic acid. Carbohydr. Polym. 2016, 140, 202–208. [Google Scholar] [CrossRef]
- Chen, H.; Hu, X.; Chen, E.; Wu, S.; McClements, D.J.; Liu, S.; Li, B.; Li, Y. Preparation, characterization, and properties of chitosan films with cinnamaldehyde nanoemulsions. Food Hydrocolloids 2016, 61, 662–671. [Google Scholar] [CrossRef]
- Li, H.; Gao, X.; Wang, Y.; Zhang, X.; Tong, Z. Comparison of chitosan/starch composite film properties before and after cross-linking. Int. J. Biol. Macromol. 2013, 52, 275–279. [Google Scholar] [CrossRef]
- Tanuma, H.; Saito, T.; Nishikawa, K.; Dong, T.; Yazawa, K.; Inoue, Y. Preparation and characterization of peg-cross-linked chitosan hydrogel films with controllable swelling and enzymatic degradation behavior. Carbohydr. Polym. 2010, 80, 260–265. [Google Scholar] [CrossRef]
- Tripathi, S.; Mehrotra, G.K.; Dutta, P.K. Physicochemical and bioactivity of cross-linked chitosan-pva film for food packaging applications. Int. J. Biol. Macromol. 2009, 45, 372–376. [Google Scholar] [CrossRef] [PubMed]
- Qiu, Y.; Qiu, L.; Cui, J.; Wei, Q. Bacterial cellulose and bacterial cellulose-vaccarin membranes for wound healing. Mater. Sci. Eng. C 2016, 59, 303–309. [Google Scholar] [CrossRef] [PubMed]
- Cacicedo, M.L.; Castro, M.C.; Servetas, I.; Bosnea, L.; Boura, K.; Tsafrakidou, P.; Dima, A.; Terpou, A.; Koutinas, A.; Castro, G.R. Progress in bacterial cellulose matrices for biotechnological applications. Bioresour. Technol. 2016, 213, 172–180. [Google Scholar] [CrossRef] [PubMed]
- Picheth, G.F.; Pirich, C.L.; Sierakowski, M.R.; Woehl, M.A.; Sakakibara, C.N.; de Souza, C.F.; Martin, A.A.; da Silva, R.; de Freitas, R.A. Bacterial cellulose in biomedical applications: A review. Int. J. Biol. Macromol. 2017, 104, 97–106. [Google Scholar] [CrossRef] [PubMed]
- Abdul Khalil, H.P.S.; Saurabh, C.K.; Adnan, A.S.; Nurul Fazita, M.R.; Syakir, M.I.; Davoudpour, Y.; Rafatullah, M.; Abdullah, C.K.; Haafiz, M.K.M.; Dungani, R. A review on chitosan-cellulose blends and nanocellulose reinforced chitosan biocomposites: Properties and their applications. Carbohydr. Polym. 2016, 150, 216–226. [Google Scholar]
- Reddy, N.; Yang, Y.Q. Citric acid cross-linking of starch films. Food Chem. 2010, 118, 702–711. [Google Scholar] [CrossRef]
- Garavand, F.; Rouhi, M.; Razavi, S.H.; Cacciotti, I.; Mohammadi, R. Improving the integrity of natural biopolymer films used in food packaging by crosslinking approach: A review. Int. J. Biol. Macromol. 2017, 104, 687–707. [Google Scholar] [CrossRef]
- Li, S.; Donner, E.; Thompson, M.; Zhang, Y.; Rempel, C.; Liu, Q. Preparation and characterization of cross-linked canola protein isolate films. Eur. Polym. J. 2017, 89, 419–430. [Google Scholar] [CrossRef]
- Salmazo, L.O.; Lopez-Gil, A.; Ariff, Z.M.; Job, A.E.; Rodriguez-Perez, M.A. Influence of the irradiation dose in the cellular structure of natural rubber foams cross-linked by electron beam irradiation. Ind. Crops Prod. 2016, 89, 339–349. [Google Scholar] [CrossRef]
- Aryaei, A.; Jayatissa, A.H.; Jayasuriya, A.C. Nano and micro mechanical properties of uncross-linked and cross-linked chitosan films. J. Mech. Behav. Biomed. Mater. 2012, 5, 82–89. [Google Scholar] [CrossRef]
- Lopez de Dicastillo, C.; Rodriguez, F.; Guarda, A.; Galotto, M.J. Antioxidant films based on cross-linked methyl cellulose and native Chilean berry for food packaging applications. Carbohydr. Polym. 2016, 136, 1052–1060. [Google Scholar] [CrossRef]
- Uranga, J.; Leceta, I.; Etxabide, A.; Guerrero, P.; de la Caba, K. Cross-linking of fish gelatins to develop sustainable films with enhanced properties. Eur. Polym. J. 2016, 78, 82–90. [Google Scholar] [CrossRef]
- Sun, S.; Liu, P.; Ji, N.; Hou, H.; Dong, H. Effects of various cross-linking agents on the physicochemical properties of starch/pha composite films produced by extrusion blowing. Food Hydrocolloids 2018, 77, 964–975. [Google Scholar] [CrossRef]
- Shang, K.; Ye, D.-D.; Kang, A.H.; Wang, Y.-T.; Liao, W.; Xu, S.; Wang, Y.-Z. Robust and fire retardant borate-crosslinked poly (vinyl alcohol)/montmorillonite aerogel via melt-crosslink. Polymer 2017, 131, 111–119. [Google Scholar] [CrossRef]
- Sacco, P.; Paoletti, S.; Cok, M.; Asaro, F.; Abrami, M.; Grassi, M.; Donati, I. Insight into the ionotropic gelation of chitosan using tripolyphosphate and pyrophosphate as cross-linkers. Int. J. Biol. Macromol. 2016, 92, 476–483. [Google Scholar] [CrossRef]
- Antunes, B.P.; Moreira, A.F.; Gaspar, V.M.; Correia, I.J. Chitosan/arginine-chitosan polymer blends for assembly of nanofibrous membranes for wound regeneration. Carbohydr. Polym. 2015, 130, 104–112. [Google Scholar] [CrossRef]
- Avcu, E.; Baştan, F.E.; Abdullah, H.Z.; Rehman, M.A.U.; Avcu, Y.Y.; Boccaccini, A.R. Electrophoretic deposition of chitosan-based composite coatings for biomedical applications: A review. Prog. Mater. Sci. 2019, 103, 69–108. [Google Scholar] [CrossRef]
- Kalantari, K.; Afifi, A.M.; Jahangirian, H.; Webster, T.J. Biomedical applications of chitosan electrospun nanofibers as a green polymer—Review. Carbohydr. Polym. 2019, 207, 588–600. [Google Scholar] [CrossRef]
- Hosseinnejad, M.; Jafari, S.M. Evaluation of different factors affecting antimicrobial properties of chitosan. Int. J. Biol. Macromol. 2016, 85, 467–475. [Google Scholar] [CrossRef] [PubMed]
- Khan, A.; Gallah, H.; Riedl, B.; Bouchard, J.; Safrany, A.; Lacroix, M. Genipin cross-linked antimicrobial nanocomposite films and gamma irradiation to prevent the surface growth of bacteria in fresh meats. Innov. Food Sci. Emerg. Technol. 2016, 35, 96–102. [Google Scholar] [CrossRef]
- Chung, Y. Effect of abiotic factors on the antibacterial activity of chitosan against waterborne pathogens. Bioresour. Technol. 2003, 88, 179–184. [Google Scholar] [CrossRef]
- Cheah, W.Y.; Show, P.L.; Ng, I.S.; Lin, G.Y.; Chiu, C.Y.; Chang, Y.K. Antibacterial activity of quaternized chitosan modified nanofiber membrane. Int. J. Biol. Macromol. 2018, 126, 569–577. [Google Scholar] [CrossRef] [PubMed]
- Wahid, F.; Hu, X.H.; Chu, L.Q.; Jia, S.R.; Xie, Y.Y.; Zhong, C. Development of bacterial cellulose/chitosan based semi-interpenetrating hydrogels with improved mechanical and antibacterial properties. Int. J. Biol. Macromol. 2019, 122, 380–387. [Google Scholar] [CrossRef] [PubMed]
- Schuerer, N.; Stein, E.; Inic-Kanada, A.; Ghasemian, E.; Stojanovic, M.; Montanaro, J.; Bintner, N.; Hohenadl, C.; Sachsenhofer, R.; Barisani-Asenbauer, T. Effects of chitosan and chitosan n-acetylcysteine solutions on conjunctival epithelial cells. J. EuCornea 2018, 1, 12–18. [Google Scholar] [CrossRef]
- Gao, P.; Wang, F.; Gu, F.; Ning, J.; Liang, J.; Li, N.; Ludescher, R.D. Preparation and characterization of zein thermo-modified starch films. Carbohydr. Polym. 2017, 157, 1254–1260. [Google Scholar] [CrossRef] [PubMed]
- Urbina, L.; Guaresti, O.; Requies, J.; Gabilondo, N.; Eceiza, A.; Corcuera, M.A.; Retegi, A. Design of reusable novel membranes based on bacterial cellulose and chitosan for the filtration of copper in wastewaters. Carbohydr. Polym. 2018, 193, 362–372. [Google Scholar] [CrossRef] [PubMed]
- Ciechańska, D. Multifunctional bacterial cellulose/chitosan composite materials for medical applications. Fibres Text. East. Eur. 2004, 12, 69–72. [Google Scholar]
- Salari, M.; Sowti Khiabani, M.; Rezaei Mokarram, R.; Ghanbarzadeh, B.; Samadi Kafil, H. Development and evaluation of chitosan based active nanocomposite films containing bacterial cellulose nanocrystals and silver nanoparticles. Food Hydrocolloids 2018, 84, 414–423. [Google Scholar] [CrossRef]
- Wang, S.; Jing, Y. Study on the barrier properties of glycerol to chitosan coating layer. Mater. Lett. 2017, 209, 345–348. [Google Scholar] [CrossRef]
- Li, X.; Zhang, H.; He, L.; Chen, Z.; Tan, Z.; You, R.; Wang, D. Flexible nanofibers-reinforced silk fibroin films plasticized by glycerol. Compos. Part. B Eng. 2018, 152, 305–310. [Google Scholar] [CrossRef]
- Zappino, M.; Cacciotti, I.; Benucci, I.; Nanni, F.; Liburdi, K.; Valentini, F.; Esti, M. Bromelain immobilization on microbial and animal source chitosan films, plasticized with glycerol, for application in wine-like medium: Microstructural, mechanical and catalytic characterisations. Food Hydrocolloids 2015, 45, 41–47. [Google Scholar] [CrossRef]
- Ubaid, M.; Murtaza, G. Fabrication and characterization of genipin cross-linked chitosan/gelatin hydrogel for ph-sensitive, oral delivery of metformin with an application of response surface methodology. Int. J. Biol. Macromol. 2018, 114, 1174–1185. [Google Scholar] [CrossRef]
- Zhang, S.; Kim, N.; Yokoyama, W.; Kim, Y. Effects of moisture content on mechanical properties, transparency, and thermal stability of yuba film. Food Chem. 2018, 243, 202–207. [Google Scholar] [CrossRef] [PubMed]
- Michaelis, M.; Brummer, R.; Leopold, C.S. Plasticization and antiplasticization of an acrylic pressure sensitive adhesive by ibuprofen and their effect on the adhesion properties. Eur. J. Pharm. Biopharm. 2014, 86, 234–243. [Google Scholar] [CrossRef] [PubMed]
- Chang, Y.P.; Abd Karim, A.; Seow, C.C. Interactive plasticizing–antiplasticizing effects of water and glycerol on the tensile properties of tapioca starch films. Food Hydrocolloids 2006, 20, 1–8. [Google Scholar] [CrossRef]
- Aguirre, A.; Borneo, R.; León, A.E. Properties of triticale protein films and their relation to plasticizing–antiplasticizing effects of glycerol and sorbitol. Ind. Crops Prod. 2013, 50, 297–303. [Google Scholar] [CrossRef]
- Liang, J.; Xia, Q.; Wang, S.; Li, J.; Huang, Q.; Ludescher, R.D. Influence of glycerol on the molecular mobility, oxygen permeability and microstructure of amorphous zein films. Food Hydrocolloids 2015, 44, 94–100. [Google Scholar] [CrossRef]
- Ren, L.; Yan, X.; Zhou, J.; Tong, J.; Su, X. Influence of chitosan concentration on mechanical and barrier properties of corn starch/chitosan films. Int. J. Biol. Macromol. 2017, 105, 1636–1643. [Google Scholar] [CrossRef]
- Kadam, D.; Lele, S.S. Cross-linking effect of polyphenolic extracts of lepidium sativum seedcake on physicochemical properties of chitosan films. Int. J. Biol. Macromol. 2018, 114, 1240–1247. [Google Scholar] [CrossRef]
- Benucci, I.; Liburdi, K.; Cacciotti, I.; Lombardelli, C.; Zappino, M.; Nanni, F.; Esti, M. Chitosan/clay nanocomposite films as supports for enzyme immobilization: An innovative green approach for winemaking applications. Food Hydrocolloids 2018, 74, 124–131. [Google Scholar] [CrossRef]
- Liang, J.; Wang, S.; Ludescher, R.D. Effect of additives on physicochemical properties in amorphous starch matrices. Food Chem. 2015, 171, 298–305. [Google Scholar] [CrossRef] [PubMed]
- Seo, J.A.; Kim, S.J.; Kwon, H.J.; Yang, Y.S.; Kim, H.K.; Hwang, Y.H. The glass transition temperatures of sugar mixtures. Carbohydr. Res. 2006, 341, 2516–2520. [Google Scholar] [CrossRef] [PubMed]
- Sterzyński, T.; Tomaszewska, J.; Andrzejewski, J.; Skórczewska, K. Evaluation of glass transition temperature of pvc/poss nanocomposites. Compos. Sci. Technol. 2015, 117, 398–403. [Google Scholar] [CrossRef]
- Ou, Y.; Sun, Y.; Guo, X.; Jiao, Q. Investigation on the thermal decomposition of hydroxyl terminated polyether based polyurethanes with inert and energetic plasticizers by dsc-tg-ms-ftir. J. Anal. Appl. Pyrolysis 2018, 132, 94–101. [Google Scholar] [CrossRef]
- Akyuz, L.; Kaya, M.; Koc, B.; Mujtaba, M.; Ilk, S.; Labidi, J.; Salaberria, A.M.; Cakmak, Y.S.; Yildiz, A. Diatomite as a novel composite ingredient for chitosan film with enhanced physicochemical properties. Int. J. Biol. Macromol. 2017, 105, 1401–1411. [Google Scholar] [CrossRef] [PubMed]
- Branca, C.; D’Angelo, G.; Crupi, C.; Khouzami, K.; Rifici, S.; Ruello, G.; Wanderlingh, U. Role of the oh and nh vibrational groups in polysaccharide-nanocomposite interactions: A ftir-atr study on chitosan and chitosan/clay films. Polymer 2016, 99, 614–622. [Google Scholar] [CrossRef]
- Hadjiivanov, K. Identification and characterization of surface hydroxyl groups by infrared spectroscopy. Adv. Catal. 2014, 57, 99–318. [Google Scholar]
- Benucci, I.; Lombardelli, C.; Cacciotti, I.; Liburdi, K.; Nanni, F.; Esti, M. Chitosan beads from microbial and animal sources as enzyme supports for wine application. Food Hydrocolloids 2016, 61, 191–200. [Google Scholar] [CrossRef]
- Peresin, M.S.; Kammiovirta, K.; Heikkinen, H.; Johansson, L.S.; Vartiainen, J.; Setala, H.; Osterberg, M.; Tammelin, T. Understanding the mechanisms of oxygen diffusion through surface functionalized nanocellulose films. Carbohydr. Polym. 2017, 174, 309–317. [Google Scholar] [CrossRef]
- Soares, F.C.; Yamashita, F.; Müller, C.M.O.; Pires, A.T.N. Thermoplastic starch/poly(lactic acid) sheets coated with cross-linked chitosan. Polym. Test. 2013, 32, 94–98. [Google Scholar] [CrossRef]
- Hejazi, M.; Behzad, T.; Heidarian, P.; Nasri-Nasrabadi, B. A study of the effects of acid, plasticizer, cross-linker, and extracted chitin nanofibers on the properties of chitosan biofilm. Compos. Part. A Appl. Sci. Manuf. 2018, 109, 221–231. [Google Scholar] [CrossRef]
- Narayanan, A.; Kartik, R.; Sangeetha, E.; Dhamodharan, R. Super water absorbing polymeric gel from chitosan, citric acid and urea: Synthesis and mechanism of water absorption. Carbohydr. Polym. 2018, 191, 152–160. [Google Scholar] [CrossRef] [PubMed]
- Aguirre-Loredo, R.Y.; Rodriguez-Hernandez, A.I.; Morales-Sanchez, E.; Gomez-Aldapa, C.A.; Velazquez, G. Effect of equilibrium moisture content on barrier, mechanical and thermal properties of chitosan films. Food Chem. 2016, 196, 560–566. [Google Scholar] [CrossRef] [PubMed]
- Vartiainen, J.; Harlin, A. Crosslinking as an efficient tool for decreasing moisture sensitivity of biobased nanocomposite films. Mater. Sci. Appl. 2011, 02, 346–354. [Google Scholar] [CrossRef]
- Fardioui, M.; Meftah Kadmiri, I.; Qaiss, A.E.K.; Bouhfid, R. Bio-active nanocomposite films based on nanocrystalline cellulose reinforced styrylquinoxalin-grafted-chitosan: Antibacterial and mechanical properties. Int. J. Biol. Macromol. 2018, 114, 733–740. [Google Scholar] [CrossRef] [PubMed]
- Ngo, D.-H.; Vo, T.-S.; Ngo, D.-N.; Kang, K.-H.; Je, J.-Y.; Pham, H.N.-D.; Byun, H.-G.; Kim, S.-K. Biological effects of chitosan and its derivatives. Food Hydrocolloids 2015, 51, 200–216. [Google Scholar] [CrossRef]

| Sample | Contact Angle/° | |
|---|---|---|
| DRY FILM | Wet Films | |
| C | 93.4 ± 0.8 | 88.8 ± 0.5 |
| CB | 91.2 ± 0.2 | 85.2 ± 1.1 |
| CB-b | 103.8 ± 1.3 | 101.3 ± 0.5 |
| CB-t | 94.7 ± 0.9 | 85.5 ± 0.4 |
| CB-bt | 99.4 ± 0.4 | 94.5 ± 0.1 |
| Samples | Water Absorption (×%) | Swelling Degree (×%) | Water Activity (Dry Films) |
|---|---|---|---|
| C | 31.9 ± 0.5 | 71.7 ± 2.4 | 0.13 ± 0.01 |
| CB | 31.1 ± 0.3 | 42.0 ± 2.0 | 0.13 ± 0.01 |
| CB-b | 28.0 ± 1.7 | 20.7 ± 1.1 | 0.14 ± 0.01 |
| CB-t | 30.9 ± 1.5 | 29.5 ± 4.3 | 0.16 ± 0.01 |
| CB-bt | 29.7 ± 0.5 | 32.4 ± 1.5 | 0.14 ± 0.01 |
| Samples | Bacteria Inhibitory Rate (×%) | Mold Inhibitory Rate (×%) | Yeast Inhibitory Rate (×%) |
|---|---|---|---|
| C | 92.4 ± 2.9 | 72.8 ± 10.7 | 100.0 ± 0.0 |
| CB | 90.8 ± 6.4 | 77.8 ± 11.4 | 95.5 ± 6.4 |
| CB-b | 85.5 ± 4.7 | 51.0 ± 8.9 | 62.9 ± 2.3 |
| CB-t | 85.0 ± 3.7 | 51.5 ± 18.6 | 65.9 ± 0.3 |
| CB-bt | 73.1 ± 2.7 | 36.9 ± 14.7 | 52.8 ± 19.6 |
© 2019 by the authors. Licensee MDPI, Basel, Switzerland. This article is an open access article distributed under the terms and conditions of the Creative Commons Attribution (CC BY) license (http://creativecommons.org/licenses/by/4.0/).
Share and Cite
Liang, J.; Wang, R.; Chen, R. The Impact of Cross-linking Mode on the Physical and Antimicrobial Properties of a Chitosan/Bacterial Cellulose Composite. Polymers 2019, 11, 491. https://doi.org/10.3390/polym11030491
Liang J, Wang R, Chen R. The Impact of Cross-linking Mode on the Physical and Antimicrobial Properties of a Chitosan/Bacterial Cellulose Composite. Polymers. 2019; 11(3):491. https://doi.org/10.3390/polym11030491
Chicago/Turabian StyleLiang, Jun, Rui Wang, and Ruipeng Chen. 2019. "The Impact of Cross-linking Mode on the Physical and Antimicrobial Properties of a Chitosan/Bacterial Cellulose Composite" Polymers 11, no. 3: 491. https://doi.org/10.3390/polym11030491
APA StyleLiang, J., Wang, R., & Chen, R. (2019). The Impact of Cross-linking Mode on the Physical and Antimicrobial Properties of a Chitosan/Bacterial Cellulose Composite. Polymers, 11(3), 491. https://doi.org/10.3390/polym11030491
